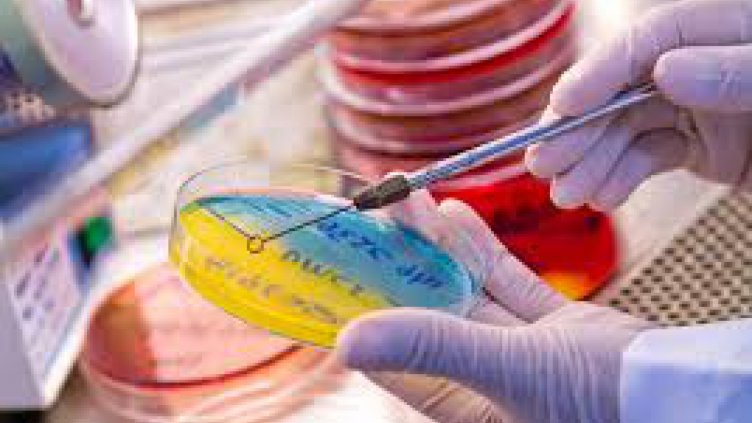
Бактерия може да помага за отслабването

Бактерията Akkermansia muciniphil, която живее в човешките черва, може да е ключът към улесняването на контрола на телесното тегло, твърдят френски изследователи от парижката болница “Питие-Салпетриер“.
Според тях става въпрос за бактерия, която представлява между 3 и 5 на сто от всички бактерии в човешките черва. Тя се свързва с диети, богати на растителни влакна, както и с ниска концентрация на захари и мазнини в кръвта.
Освен това намалява риска от затлъстяване, диабет и болести на сърцето. Akkermansia muciniphil би могла да се използва при лечението на болести на метаболизма.
Тези данни са били събрани след тестове върху 49 души с наднормено тегло, пише Tribali.info.

Отбелязваме Световния ден на недоносените бебета с редица инициативи
Отбелязваме Световния ден на недоносените бебета с редица инициативи  Депутатите от комисиите в НС разглеждат бюджета за 2026 г.
Депутатите от комисиите в НС разглеждат бюджета за 2026 г.  Над 2,5 млн. жилища в Украйна са недостъпни, 10,6 млн. души са напуснали домовете си
Над 2,5 млн. жилища в Украйна са недостъпни, 10,6 млн. души са напуснали домовете си  Луната в Скорпион подобрява живота на три зодии след 17 ноември
Луната в Скорпион подобрява живота на три зодии след 17 ноември 
 Най-тъмните места в Слънчевата система и във Вселената
Най-тъмните места в Слънчевата система и във Вселената  Изненадващ обрат в магнитното поле на Земята
Изненадващ обрат в магнитното поле на Земята  Китай откри най-голямото находище на злато от 1949 г.
Китай откри най-голямото находище на злато от 1949 г.  Телескопът James Webb изготви първия „метеорологичен доклад“ за екзопланета
Телескопът James Webb изготви първия „метеорологичен доклад“ за екзопланета 
 Георги Костадинов пред голямо постижение в Левски
Георги Костадинов пред голямо постижение в Левски  В Турция се подиграха на България, акцентираха и върху автогола на Чернев
В Турция се подиграха на България, акцентираха и върху автогола на Чернев  Левски затръшна вратата пред свой играч
Левски затръшна вратата пред свой играч  Веласкес посочи голям проблем на Левски
Веласкес посочи голям проблем на Левски 
 5 храни, които блокират горенето на мазнини при жените 40+
5 храни, които блокират горенето на мазнини при жените 40+  Подуване и газове? 5 билки спасяват положението
Подуване и газове? 5 билки спасяват положението  Желязо, В12 и още нещо: формулата за силно женско тяло
Желязо, В12 и още нещо: формулата за силно женско тяло  Кето хляб без брашно
Кето хляб без брашно 
 Кардиометаболитните заболявания набират все по-голяма честота на разпространение
Кардиометаболитните заболявания набират все по-голяма честота на разпространение  Миелоидните клетки – неочакван съюзник в борбата срещу рака
Миелоидните клетки – неочакван съюзник в борбата срещу рака  Какво показва ехографията на щитовидната жлеза и кога се налага биопсия?
Какво показва ехографията на щитовидната жлеза и кога се налага биопсия?  Повече от половината хора с диабет в света остават недиагностицирани
Повече от половината хора с диабет в света остават недиагностицирани 
 дава под наем, Едностаен апартамент, 20 m2 София, Лозенец, 200 EUR
дава под наем, Едностаен апартамент, 20 m2 София, Лозенец, 200 EUR  дава под наем, Тристаен апартамент, 90 m2 Варна, Гръцка махала, 700 EUR
дава под наем, Тристаен апартамент, 90 m2 Варна, Гръцка махала, 700 EUR  дава под наем, Зала, 60 m2 София, Борово, 30.68 EUR
дава под наем, Зала, 60 m2 София, Борово, 30.68 EUR  дава под наем, Офис, 83 m2 Пловдив, Център, 600 EUR
дава под наем, Офис, 83 m2 Пловдив, Център, 600 EUR 













 „Димитър Маджаров“ инвестира над 2,3 млн. лв. в пречиствателна станция и опаковъчна машина
„Димитър Маджаров“ инвестира над 2,3 млн. лв. в пречиствателна станция и опаковъчна машина  Отбелязваме Световния ден на недоносените бебета с редица инициативи
Отбелязваме Световния ден на недоносените бебета с редица инициативи  Тръмп вече иска документите по делото на Епстийн да бъдат публикувани
Тръмп вече иска документите по делото на Епстийн да бъдат публикувани  Херо започва в Ботев Пловдив днес
Херо започва в Ботев Пловдив днес  Опасна ли е покупката на автомобил от първи собственик
Опасна ли е покупката на автомобил от първи собственик  Сара Джесика Паркър с почетна награда „Златен глобус“ за изключителен принос към телевизионната индустрия
Сара Джесика Паркър с почетна награда „Златен глобус“ за изключителен принос към телевизионната индустрия
Коментари